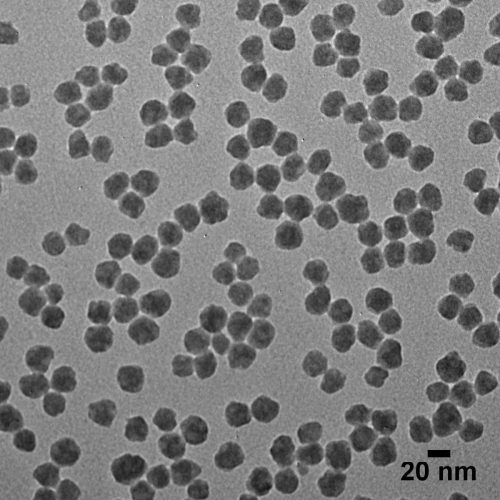
Solid Silica in DI Water - Silica Nanospheres - 5 mg/mL

Home » nanoparticles, » Page 7
nanoparticles,
Showing 55–61 of 61 results
-

Silica Nanoparticles, 750 nm, Dry Powder
$0.00 -

Silica Nanoparticles, 800 nm, Dry Powder
$0.00 -

Silica Nanoparticles, 850 nm, Dry Powder
$0.00 -

Silica Nanoparticles, 900 nm, Dry Powder
$0.00 -

Silica Nanoparticles, 950 nm, Dry Powder
$0.00 -

Solid Silica in DI Water – Silica Nanospheres – 5 mg/mL
$350.00 -

Solid Silica in Ethanol – Silica Nanospheres – Aminated – 10 mg/mL
$350.00
- Home
- Air Technologies
- AP Series Foggers
- CRF Series Foggers
- Airflow Testing Instruments
- Dust Monitors
- Portable Foggers
- Comparisons Of Cleanroom Foggers for Smoke Studies
- CRF Series Ultrasonic Foggers
- AP Series Ultrapure Foggers
- AP30 Ultrapure Cleanroom Fogger
- AP35 Ultrapure Cleanroom Fogger
- AP50 Ultrapure Cleanroom Fogger – High-Performance LN₂ Fogging for Airflow Visualization & Validation
- AP100 Cleanroom Ultrapure Fogger-bundle
- AP100 Ultrapure Fogger
- AP200 Ultrapure Cleanroom Fogger – Maximum Fog Volume for Large-Scale Cleanroom Validation
- Cleanroom Foggers
- Decontamination Foggers
- Fogger Accessories
- Indoor Air Quality Monitors
- Microbial Air Samplers
- Particle Counters
- Portable Clean Environment
- Metrology
- Wafer Standards
- Microspheres
- Polystyrene Microspheres
- Polystyrene- NIST SRM, 60.4 nm-895 nm
- 2000 Series Uniform Polymer Particles
- PSL Size Standards- OptiBind, 0.1 μm-2.5 μm
- PSL Size Standards- Hepa Test, 30nm-3.1μm
- PSL Size Standards- Hepa Check, 0.12 μm-0.30 μm
- Ezy-Cal™ Count Precision Size Standards
- 7000 Series Copolymer Microsphere Suspensions
- Dri-Cal Particle Size Standards Beads
- Count-Cal Count Precision Size Standards
- 3000 Series Nanosphere, 20 nm-900 nm
- 4000 Series Monosized Beads
- 4000 Series Dry Monosized Beads
- Polystyrene, 100 nm-100 μm
- Polystyrene 3k-4k
- Surf-Cal, Particle Size Standards
- Silica and Glass
- Polystyrene Puffs
- Polystyrene Microspheres
- Laboratory and Medical Equipment
- Water Technologies
- ÅP Semiconductor